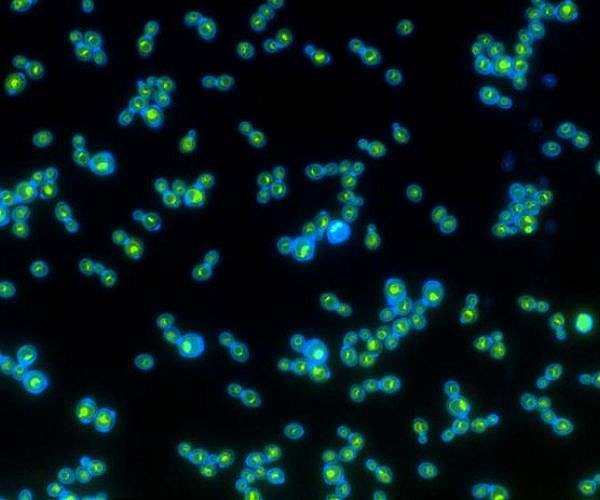
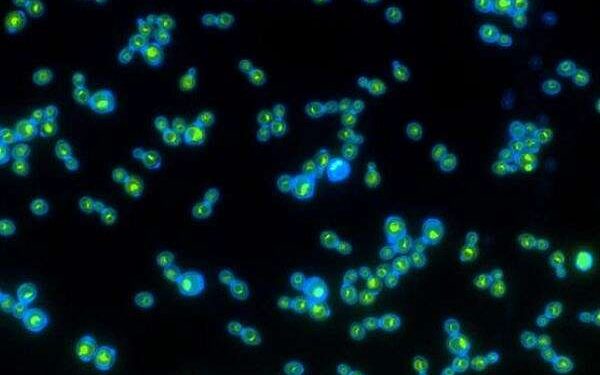
Yeast withstands Mars-like shocks and toxic salts in survival test

Yeast withstands Mars-like shocks and toxic salts in survival test
by Simon Mansfield
Sydney, Australia (SPX) Oct 15, 2025
Life on Mars, if it ever existed, would need to survive an environment defined by violence and toxicity – from meteorite impacts to soil laced with corrosive perchlorate salts. Now, scientists at the Indian Institute of Science (IISc) have found that even simple organisms like yeast can endure these punishing conditions by activating ancient stress-response systems.
Led by molecular biologist Purusharth I. Rajyaguru, the research team tested the resilience of Saccharomyces cerevisiae, a model yeast species long used in biological studies and previously flown on space missions. The experiments reveal how this single-celled organism reorganizes its internal machinery to cope with sudden physical and chemical shocks that mimic those on the Martian surface.
Using the High-Intensity Shock Tube for Astrochemistry (HISTA) at the Physical Research Laboratory in Ahmedabad, the scientists exposed yeast to simulated meteorite impacts – shock waves traveling at 5.6 times the speed of sound. Even after these intense bursts, many cells survived, though their growth slowed. The yeast also tolerated exposure to 100 millimolar sodium perchlorate (NaClO4), a salt concentration similar to what has been detected in Martian regolith.
Remarkably, the microorganisms endured when subjected to both stressors at once. Under these conditions, the yeast cells produced specialized molecular assemblies called ribonucleoprotein (RNP) condensates. These structures, which include stress granules and P-bodies, are known to protect RNA and regulate protein synthesis during periods of extreme stress.
The researchers observed that shock waves triggered the formation of both stress granules and P-bodies, while perchlorate exposure led only to P-body formation. Yeast mutants unable to assemble these RNP condensates fared poorly, underscoring their critical role in cellular defense. Transcriptome analyses further identified RNA transcripts that were disrupted by Mars-like conditions, offering clues to the underlying molecular pathways of survival.
According to the team, these findings highlight how fundamental stress responses – shared by yeast, humans, and other life forms – may offer a blueprint for understanding how biology adapts to extraterrestrial environments.
Research Report:Ribonucleoprotein (RNP) condensates modulate survival in response to Mars-like stress conditions
Related Links
Indian Institute of Science (IISc)
Mars News and Information at MarsDaily.com
Lunar Dreams and more